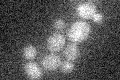
YDR488C
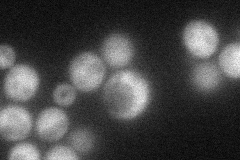
YDR488C
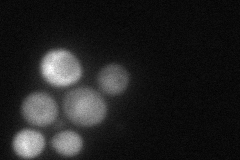
YDR488C
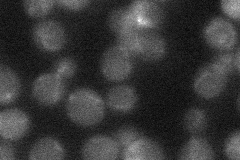
YDR488C
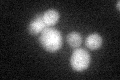
YDR488C

View description
Dynein intermediate chain, acts in the cytoplasmic dynein pathway, forms cortical cytoplasmic microtubule capture site with Num1p; null mutant is defective in nuclear migration, essential in the absence of CIN8
Localization:
Intensity:
Fold change:
Significance:
-
C’ GFP library in SD
below threshold14.73 -
N' NOP1pr-GFP in SD
cytosol55.7553 -
N' TEF2pr-mCherry in SD
cytosol80.5476 -
N' NATIVEpr-GFP in SD
cytosol21.8924 -
N' TEF2pr-VC and Cyto-VN in SD

#N/A0 -
C’ GFP library in SD+DTT
cytosol16.91.14No -
C’ GFP library in SD+H2O2

cytosol16.831.14No -
C’ GFP library in Starvation Media

cytosol17.861.21No -
C’ GFP library on the background of Pup2-DaMP

N/A -
C’ GFP library on the background of CCT mutant

N/A0N/AYes
